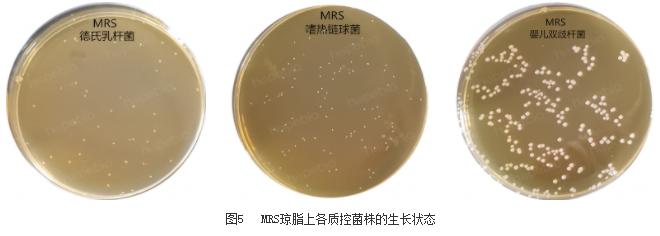
鉴定乳酸菌的常用的培养基是什么,乳酸菌微生物检测
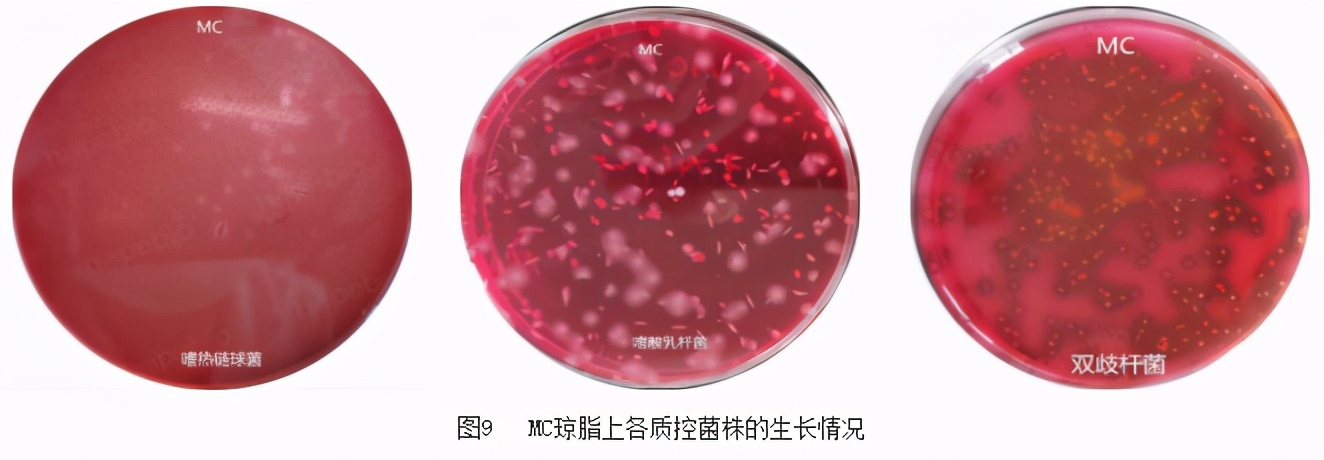
鉴定乳酸菌的常用的培养基是什么,乳酸菌微生物检测

一、乳酸菌介绍: 乳酸菌是一类可发酵糖类产生大量乳酸的、无芽孢、革兰氏阳性细菌的通称。 主要有乳杆菌属(Lactobacillus)、双歧杆菌属(Bifidobacterium)和嗜热链球菌属(Streptococcus)、明串珠菌属(Leuconostoc)和片球菌属(Pediococcus)。
乳杆菌属菌体形态多样,呈长杆状、弯曲杆状或短杆状(图1)。

双歧杆菌呈短杆状、纤细杆状或球形,可形成各种分支或分叉等多形态,如Y字形、v字形、弯曲状、勺形(图2),典形形态为分叉杆菌,因而取名bifidus,不抗酸,无动力。

嗜热链球菌菌体呈球形、卵圆形或球杆状,直径为0.5μm~2.0μm,成对或成链排列(图3)。

二、检验标准和程序:
《GB4789.35-2016食品安全国家标准 食品微生物学检验 乳酸菌检验》中规定,乳酸菌的检验程序如下:

图4 乳酸菌检验程序
该检验程序中,共涉及3种培养基,本文将对它们分别进行详细阐述。
三、主要培养基: 1、MRS培养基: 该产品主要用于食品中乳酸菌的分离培养和计数。
培养基成分(g/L)如下:
|
蛋白胨 |
10.0 |
|
牛肉浸粉 |
5.0 |
|
酵母浸粉 |
4.0 |
|
葡萄糖 |
20.0 |
|
磷酸氢二钾 |
2.0 |
|
柠檬酸三铵 |
2.0 |
|
醋酸钠 |
5.0 |
|
硫酸镁 |
0.2 |
|
硫酸锰 |
0.05 |
|
琼脂 |
15.0 |
|
吐温80 |
1.0 |
|
pH值6.2±0.2 |
25℃ |
原理: 蛋白胨、牛肉膏粉、酵母膏粉提供氮源、维生素、生长因子;葡萄糖为可发酵糖类;磷酸氢二钾为酸碱缓冲剂;柠檬酸三铵、硫酸镁、硫酸锰、吐温-80和醋酸钠为培养各种乳酸菌提供生长因子,其成分还能抑制某些杂菌并中和细胞毒性物质,为乳酸菌提供一个良好的生长环境;琼脂是培养基的凝固剂。 用法: 称取本品66.2g,加热溶解于1000mL蒸馏水中,分装,121℃高压灭菌15-20分钟,备用。 质控: 按标签用法制备培养基,接种质控菌株,放置36±1℃需氧培养48±2小时,观察结果(表1、图5)。

表1 MRS培养基上各质控菌株的生长情况要求
2、莫匹罗星锂盐和半胱甘酸盐酸盐改良MRS培养基: 顾名思义,就是通过添加某些成分对MRS培养基进行了改良。其基础与MRS相同,使用HB0384-5或HB0384-6都可以,每200mL培养基中加入过滤除菌的莫匹罗星锂盐10mg和半胱氨酸盐酸盐0.1g。使用海博公司的产品的实际添加量为: 莫匹罗星锂盐(HB0384-6a):1支/100mL; 半胱氨酸盐酸盐(HB0384-11a):1支/200mL。 原理: 莫匹罗星是一种抗生素,主要用于杀灭皮肤表面的革兰氏阳性球菌,对一些革兰氏阴性细菌有一定的抗菌作用(图6)。加入本培养基中,可以抑制乳杆菌和嗜热链球菌等杂菌的生长。

L-半胱氨酸是一种具有生理功能、在自然界广泛存在的重要物质。它在动植物体内是各组织细胞用来防御有害物质和增加活力的一种氨基酸,并且是唯一具有活性巯基(-SH)的氨基酸,具有促进蛋白质合成、刺激生长、增加脂肪分解、增强免疫的作用,添加在该产品中,可以使培养基维持较低的氧化还原电位,促进厌氧菌双歧杆菌的生长(图7)。

用法: 称取本品66.2g,加热溶解于1000 mL蒸馏水中,分装,121℃高压灭菌15-20分钟,冷至48℃左右时,每200 mL培养基中加入过滤除菌的莫匹罗星锂盐10mg和半胱氨酸盐酸盐0.1g,混匀,倾入无菌平皿,备用。 质控: 按标签用法制备培养基,接种以下质控菌株,放置36±1℃厌氧培养48±2小时,观察结果(表2、图8)。

表2 改良MRS培养基上各质控菌株的生长情况要求

图8 改良MRS培养基上各质控菌株的生长状态
3、MC琼脂培养基: 该培养基主要用于食品中嗜热链球菌总数测定。
成分(g/L)如下 :
|
大豆蛋白胨 |
5.0 |
|
牛肉浸粉 |
3.0 |
|
酵母浸粉 |
3.0 |
|
葡萄糖 |
20.0 |
|
乳糖 |
20.0 |
|
碳酸钙 |
10.0 |
|
琼脂 |
15.0 |
|
中性红 |
0.05 |
|
pH值6.0±0.1 |
25℃ |
原理: 大豆蛋白胨、牛肉膏粉和酵母膏粉能提供氮源、维生素和生长因子;葡萄糖和乳糖为可发酵糖类提供碳源;乳酸菌发酵糖产酸使菌落周围碳酸钙溶解,以辨别乳酸菌;琼脂是培养基的凝固剂;中性红为pH指示剂。 用法: 称取本品80.0g,加热煮沸溶解于1000mL蒸馏水中,121℃高压灭菌15分钟,备用。 质控: 按标签用法制备培养基,接种以下质控菌株,放置36±1℃需氧培养48±2小时,观察结果(表3、图9)。

表3 MC琼脂上各质控菌株生长的要求
四、乳酸菌的生化鉴定: 有时为了确定菌种的种类和纯度,需要对接种的菌种或分离出的菌株做进一步鉴定,乳酸菌最常用的生化鉴定方法就是碳水化合物的生化反应,下面对三种乳酸菌的生化反应现象逐一说明。相关表格引自《GB4789.35-2016食品安全国家标准 食品微生物学检验 乳酸菌检验》和《GB4789.34-2016食品安全国家标准 食品微生物学检验 双歧杆菌检验》。 1、乳杆菌的碳水化合物反应 常见乳杆菌的碳水化合物反应标准和现象如表4。

2、嗜热链球菌的生化反应 常见嗜热链球菌的主要生化反应标准和现象如表5。表5 常见嗜热链球菌的主要生化反应

3、双歧杆菌的主要生化反应 常见双歧杆菌的主要生化反应标准和现象如表6。表6 常见双歧杆菌的主要生化反应

五、注意事项: 在乳酸菌检验中,需要注意的地方有两个,其一为样品处理方式,其二为生化试验细节。 1、样品的稀释,遵循常规用量,即25.0g/mL样品加入225g/mL生理盐水中进行稀释。但是对于冷冻样品,在稀释之前首先要进行解冻,对于解冻方式,标准作了明确规定:2-5℃条件下解冻,应少于18h或低于45℃条件下15分钟内解冻完毕,然后进行下一步操作。 2、在进行生化反应的过程中需要注意: (1)接菌:必须为培养基平板纯培养出的新鲜培养物; (2)覆盖石蜡:标准中规定,对于厌氧菌要加入液体石蜡后进行培养,但实际试验表明,不管对于兼性厌氧菌还是严格厌氧菌,加不加石蜡结果均一致,这个并不影响结果的判断,操作时尽量按照标准要求即可。 (3)培养时间:通常18h即可观察结果,现象不明显者可适当延长至24h。 (4)标准比对:对于有些生化反应,虽然标准中列出呈阳性或阴性反应,但实际试验时并不能一定得到这种结果,也就是不能与标准达到100%的符合,这并不是生化管产品的问题,可能是菌株差异所致,因为标准中所描述的阳性和阴性反应,都是以90%以上的菌株为范围的(如图10),并不是绝对所有的菌株都能达到这种反应。对于偶尔出现的这种现象,要理性对待,可以视情况选择其他的鉴定方法,对鉴定结论相互印证。

图10 标准中对于生化反应符合性的备注说明
补充说明:
该标准涉及的内容较多,本次列出的是常规性的一些内容,有关计数方式和培养基的具体选择问题,将在后续的文章中继续探讨。
《GB 4789.35-2016 乳酸菌检验》-标准*载下**
http://www.hopebiol.com/biaozhun-download.asp?id=68
《GB 4789.34-2016 双歧杆菌检验》-标准*载下**
http://www.hopebiol.com/biaozhun-download.asp?id=67
注:本文属海博生物原创,未经允许不得转载。